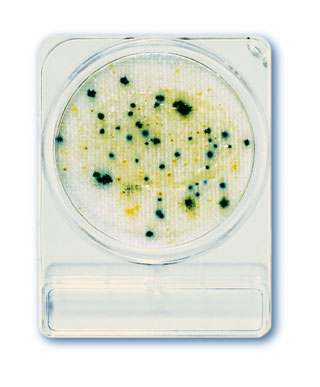
Compact Dry CF
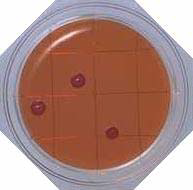
Desoxycholate Agar - Food Stamp
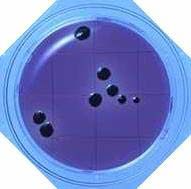
MLCB Agar - Food Stamp
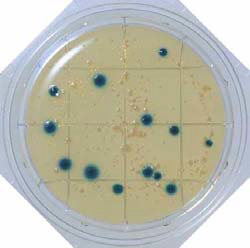
X-GAL Agar- Food Stamp
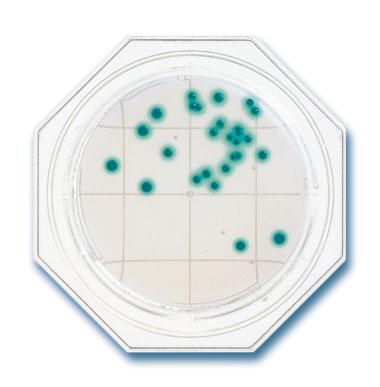
X-SA Agar - Food Stamp

Laitteet
Kauppa > Mikrobiologia ja hygieniakontrolli
Hygieniakontrollilaitteet
Luminometrit
For ATP and AMP measurements
Reliable monitoring of liquids, dry and moist surfaces.
1. Very simple and safe to operate
2. Patented simultaneous measurement of AMP and ATP for increased sensitivity
3. Patented and detergent-tolerant luciferase for validated results
4. Patented cycle technology increases the luminescence stability and extends
the signal
5. The world's lightest and smallest device
6. Extremely fast and accurate measuring method
Accessories to be used with Lumitester PD30
LuciPacPen/ LuciPacPen AQUA / LuciPacPen LS (Long Swab)
LuciPac Pen:For dry and moist surfaces
LuciPac Pen AQUA: For liquids and water
LuciPac Pen LS: For endoscopes and hard-to-access locations
• Heat-sealed and unbreakable swab
• Swabs can be removed individually from resealable packaging
• Detergent-tolerant enzymes – low inhibition from detergent residues
• High stability of swab at room temperature
• Greatest sensitivity due to patented simultaneous measurement of AMP and ATP
• Shelf life: 15 months at 2 – 8°C; 14 days at 25°C; 5 days at 30°C. The product has a shelf life of up to 30 days at temperatures of 20°C or less.
If the swabs are cooled again, the labelled shelf life of 15 months then reapplies
Lumitester C-110
For ATP and microbial biomass measurements
Lumitester C-110 is a small, lightweight and precision instrument for ATP measurement.
Using special reagents "CheckLite" series, this instrument helps to streamline and
speed up hygenic control rangingwidely from hygiene monitoring to microbial detection.
Its performance is adequate to use as the luminometer for biochemical research.
Besides adjustable measurement time, it is comparable in sensitivity and dynamic range
to the expensive bench-top luminometers.
Read more
Accessories to be used with Lumitester C-110
CheckLite -
For ATP measurements
250 (Product code: 61304)
250 Plus (Product code: 61305)
ATP Eliminating Enzyme -
Microbial biomass assay(Product code: 61306)
High sensitive microbial biomass assayHS Set (Productcode: 61310)
Aceptic test for aceptic packed food products and beverages
AT100/Milk (Productcode: 61312)
Coliform test
CT150 (Product code: 61328)

Ympäristössä esiintyville sienille.
Sabouraud-agar jossa kloramfenikolia, 25 cm²
150 maljaa/pakkaus (1000199)
Sabouraud-agar jossa kloramfenikolia, 25 cm²
150 maljaa/pakkaus (1000199)

Bacillus cereus-bakteerille
10 cm²
Minimitilaus 2 kpl
10 cm²
Minimitilaus 2 kpl

Heterotrofisille bakteereille
Koliformeille

Koliformeille ja E.colille

Kromogeeninen alusta E.coli-bakteerin määrittämiseen (22-24 tuntia)

Enterobakteereille

Enterokokille

Listeria-bakteereille

Pseudomonas aeruginosa-bakteerille

Salmonellan varmistamiseen esikasvatuksen jälkeen

Kokonaispesäkelaskentaan

Katekiiniä sisältäville tuotteille

Vibrio parahaemolyticus-bakteerille

Kromogeeninen alusta Bacillus cereus-bakteerille

Kromogeeninen alusta Staphlycoccus aureus-bakteerille

Hiivoille ja homeille
Minimitilaus 2 kpl
Minimitilaus 2 kpl

Hiivojen ja homeiden nopeaan määrittämiseen (48-72 tuntia)

Psedomonakselle (setrimidi, kanamysiinisulfaatti, nalidiksiini)
10 cm²
30 maljaa/pakkaus (1000201)
10 cm²
30 maljaa/pakkaus (1000201)

Soija-kaseiini-agar
10 cm²
30 maljaa/pakkaus (1000182)
10 cm²
30 maljaa/pakkaus (1000182)

SCD agar (lesitiini, polysrorbaatti 80)
10 cm²
10 cm²
Koloformeille
10 cm²
Minimitilaus 2 kpl
10 cm²
Minimitilaus 2 kpl

ECBlue on yksinkertainen, nopea ja luotettava testi koliformien ja E.colin kvalitatiiviseen ja kvantativviseen määrittämiseen vedestä.
1 x 18 määritystä (1001020)
1 x 18 määritystä (1001020)

Kiinteän läpötilan inkubaattori 35 +/- 2°C. Integroitu helposti luettava lämpömittari.
Kapasitetti n. 60 pinottua Food Stamp- tai 50 Compact Dry-maljaa. Hyllyt tilattava erikseen.
(1000048)
Kapasitetti n. 60 pinottua Food Stamp- tai 50 Compact Dry-maljaa. Hyllyt tilattava erikseen.
(1000048)

Mikrobeille ja soluille. (61911)

Hygieniamonitorointiin käyttäen ATP-AMP-mittausta (1402653)

100 puikkoa/pakkaus ( 20 x 5 kpl) (1802655)

100 puikkoa/pakkaus ( 20 x 5 kpl) (1802656)

100 puikkoa/pakkaus ( 20 x 5 kpl) (1402656)

100 puikkoa/pakkaus ( 20 x 5 kpl) (1402655)

Stafylokokeille
10 cm²
100 maljaa/pakkaus (1000179)
10 cm²
100 maljaa/pakkaus (1000179)
Salmonellalle
10 cm²
Minimitilaus 2 kpl
10 cm²
Minimitilaus 2 kpl

MRSA-bakteereille
10 cm²
30 maljaa/pakkaus (1061342)
10 cm²
30 maljaa/pakkaus (1061342)

Ruokamyrkytyksiä aiheuttaville sienille
10 cm²
Minimitilaus 2 kpl
10 cm²
Minimitilaus 2 kpl

Sabouraud-agar jossa kloramfenikolia
25 cm²
150 maljaa/pakkaus (1000199)
25 cm²
150 maljaa/pakkaus (1000199)

SCDLP-agar, jossa inaktivoivia ainesosia
10 cm²
30 maljaa/pakkaus (1000198)
10 cm²
30 maljaa/pakkaus (1000198)

Kokonaispesäkelaskentaan
10 cm²
Minimitilaus 2 kpl
10 cm²
Minimitilaus 2 kpl

Vibrio parahaemolyticus-bakteerille
10 cm²
Minimitilaus 2 kpl
10 cm²
Minimitilaus 2 kpl

Staphylococcus aureus-bakteerille
10 cm²
Minimitilaus 2 kpl
10 cm²
Minimitilaus 2 kpl
Koliformeille
10 cm²
Minimitilaus 2 kpl
10 cm²
Minimitilaus 2 kpl

E.coli -bakteerille ja koliformeille
10 cm²
Minimitilaus 2 kpl
10 cm²
Minimitilaus 2 kpl
Staphylococcus aureus-bakteerille
10 cm²
Minimitilaus 2 kpl
10 cm²
Minimitilaus 2 kpl
